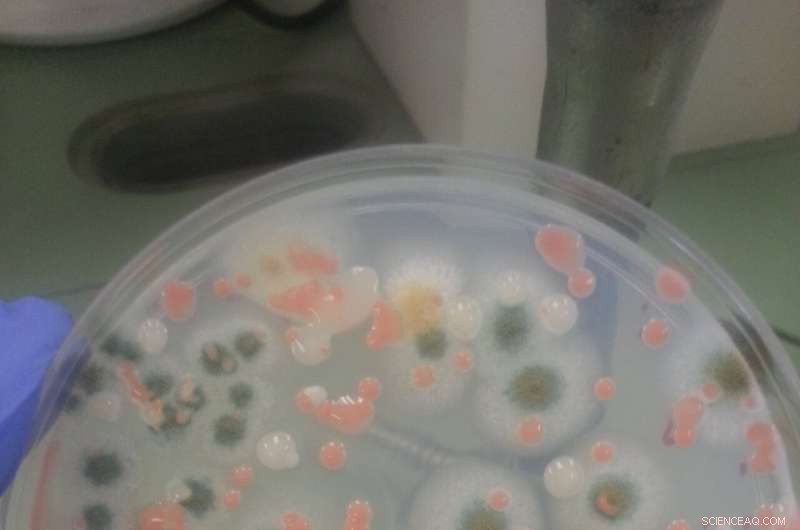
Innovative Self‑Cleaning Surfaces for Spacecraft to Neutralize Microbial Threats

Fungi observed on the ISS, growing on a panel of the Russian Zarya Module where exercise clothes were hung to dry. Credit: NASA/ESA
Astronauts live and work in orbit along with teeming populations of microorganisms, which could present a serious threat to health—and even the structural integrity of spacecraft. To help combat such invisible stowaways, an ESA-led project is developing microbe-killing coatings suitable for use within spacecraft cabins.
Crewmen on the International Space Station are not alone. A microbial survey of surfaces within the orbital outpost found dozens of different bacteria and fungi species, including harmful pathogens such as Staphylococcus aureus—known to cause skin and respiratory infections as well as food poisoning.
These microbial populations could even make spacecraft sick, not just astronauts. Bacteria and fungi produce "biofilms"—akin to the plaque on your teeth—that can in turn tarnish and eat away at metal and glass as well as plastic and rubber.
This problem proved acute in the latter days of the ISS's predecessor, the Mir space station, where microbial colonies were observed growing on parts of spacesuits, cable insulation and even the seals of windows.
"With astronauts' immune systems suppressed by microgravity, the microbial populations of future long-duration space missions will need to be controlled rigorously," explains ESA material engineer Malgorzata Holynska. "So ESA's Materials' Physics and Chemistry Section is collaborating with Istituto Italiano di Tecnologia, IIT, to study antimicrobial materials that could be added to internal cabin surfaces."

ESA project PATINA with IIT has begun work on titanium oxide, also known as 'titania', used for example in self-cleaning glass down here on Earth, as well as in hygienic surfaces. When titanium oxide is exposed to ultraviolet light, it breaks down water vapour in the air into 'free oxygen radicals', which eat away whatever is on the surface, including bacterial membranes. Credit: IIT
The IIT team has begun work on titanium oxide, also known as "titania," used for example in self-cleaning glass down here on Earth, as well as in hygienic surfaces. When titanium oxide is exposed to ultraviolet light, it breaks down water vapor in the air into "free oxygen radicals," which eat away whatever is on the surface, including bacterial membranes.
"Bacteria gets inactivated by the oxidative stress generated by these radicals," says Mirko Prato of IIT. "This is an advantage because all the microorganisms are affected without exception, so there is no chance that we increase bacterial resistance in the same way as some antibacterial materials."
The choice of titanium oxide was guided by previous research into antimicrobial coatings for hospitals. The team are probing method to "dope" the compound; tweaking its recipe to increase its sensitivity to the visible portion of the light spectrum.
"Antimicrobial coatings on Earth often make use of silver, but we want to do without it here," adds Malgorzata. "The issue is that in the confined environment of a spacecraft, prolonged exposure to silver could have negative health effects for astronauts—we don't want a heavy metal buildup in the onboard water, for instance, with soluble silver linked to skin and eye irritation, even changes in skin color at very high doses."
One of the attractions of titanium oxide as an alternative is its apparent long-term stability, explains Fabio Di Fonzo of IIT: "But we will be performing artificial aging of coatings to see how they evolves over time. And part of the project results will be to see what are the photo-degradation products going back into the cabin atmosphere once the bacteria are oxidized—obviously we don't want end products that are more toxic than the microbes themselves."
A petri dish contains colonies of fungi grown from a sample collected aboard the International Space Station during the first of NASA's three Microbial Tracking-1 flights. Credit: NASA/JPL
Testing by IIT has achieved successful titanium oxide coating of a variety of candidate surfaces: glass, silicon wafer, aluminum foil and even clean-room grade paper tissue. The coatings are put in place using various methods, including "physical vapor deposition" and "atomic layer deposition"—involving the gradual laying down of thin films by exposure to gaseous chemicals, techniques more traditionally employed for fabricating semiconductor devices.
"We aim to keep this antimicrobial layer as thin as possible, so as not to alter the mechanical properties of underlying materials too much, not to stop fabrics from bending and so on," says Mirko "We are targeting thicknesses of 50 to 100 nanometers, millionths of a millimeter."
The PATINA project, 'Optimization of Photo-catalytic Antibacterial coatings' was proposed through ESA's Open Space Innovation Platform, seeking out novel ideas for space research from any source. The project also covers other antimicrobial surface treatments, including super-hydrophobic materials that repel all moisture, electro-static reaction and biocide-releasing materials.
At ESTEC, ESA Research Fellow Mengjiao Wang performed work on testing coatings, now succeeded by Research Fellow Federica Arena.
This new antimicrobial approach complements existing European research such as the French space-surface experiment MATISS and the German Touching Surfaces experiment investigating bacterial growth aboard the ISS. + Explore further